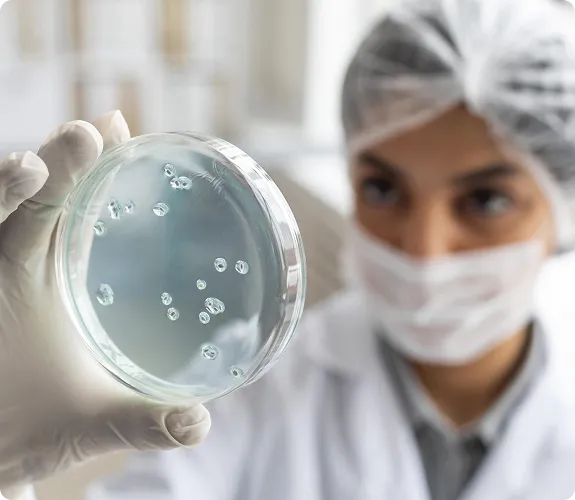

Customised DNA Extraction Workflows for Microbial Genomics Laboratories
DNA extraction workflows designed for microbial genomics laboratories. Azora Biosciences develops solutions tailored to the unique challenges of microbial samples, including diverse organisms, complex matrices, and demanding downstream applications.
From environmental and clinical samples to high-throughput microbial testing workflows, our solutions integrate seamlessly into your existing processes—delivering consistent yield, purity, and reproducibility.
Suitable for extraction workflows handling 100,000 > 5 million + extractions per year
Metagenomic, Whole Genome, and Amplicon sequencing workflows developed specifically for your microbial sample types
Proven DNA quality for challenging matrices, including biofilms, environmental swabs, and complex microbiome samples
Is A Tailor-Made DNA Extraction Solution Right For You?
- Moving from 16S/ITS PCR-based workflows to shotgun metagenomics or WGS pipelines?
- Scaling up your clinical or environmental sequencing capacity while managing extraction costs?
- Seeking a cost-effective workflow for high-volume screening programs?
If any of the above are true for your laboratory, a customised microbial DNA extraction solution will be the most efficient and cost-effective option for your workflows.
Benefits Of A Customised DNA Extraction Solution
More cost-effective than “off-the-shelf” kits for high-throughput microbial testing
Optimised for your sample type and sequencing platform, ensuring maximum DNA purity and consistency
Improved operational efficiency, reducing reagent waste and hands-on time
A Model Trusted by The World's Leading Genomics Organisations
We have been impressed by the quality of the genomic DNA extractions Azora Biosciences have provided us for our grapevine research-they exhibit impressive compatibility with our Oxford Nanopore sequencing platform. The professionalism and responsiveness of the Azora team is also outstanding. We have recommended their services to others and will continue to do so

Dr Annabel Whibley
Bioinformatician, Bragato Research Institute
For our plant genomics work, achieving consistently high-quality DNA extractions at scale is critical. The customized DNA extraction workflow developed by Azora Biosciences delivers high-performance results while integrating seamlessly with our existing high-throughput equipment platform.

Albertina Gauna
BR Biotechnology Coordinator
GDM Seeds
In a high-throughput lab such as ours, reduction or elimination of preparation and process steps soon adds up to significant time savings, especially where that time is hands-on. Likewise, any reduction in plasticware going to recycling or landfill is a welcome addition to our carbon footprint reduction efforts. The custom kit from Azora Biosciences has enabled us to make significant improvements in both areas

Asta Maharajh
Team Leader, Genemark Laboratory
Our molecular team was looking for an automated DNA extraction kit for honey PCR workflows. The Azora extraction kit provided the cleanest DNA and was the most cost-effective solution for our business. Sample repeats are now rare and labour costs have dropped significantly. The local technical support and service has been excellent, and we will continue to enjoy working with Azora.

Jonno Hill
Chief Executive Officer, Hill Laboratories
Browse Extraction Performance Datasets
The Customisation Process

- Discovery
Virtual meeting to understand current workflow, requirements, objectives and contraints

- Proposals
We prepare a detailed proposal outlining the recommended solution, protocol, costs, and timelines

- Custom Development
We develop and validate a custom DNA extraction solution using our proprietary chemistry platforms and validated component libraries

- Client Trial
Your tailored extraction system is supplied for in-house validation and performance testing
Start with a no-obligation consultation